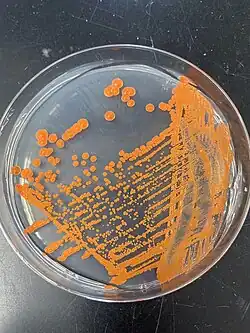

Phaffia
| Phaffia | |
|---|---|
| |
| Culture of Phaffia rhodozyma on PDA plate | |
| Scientific classification | |
| Kingdom: | Fungi |
| Division: | Basidiomycota |
| Class: | Tremellomycetes |
| Order: | Cystofilobasidiales |
| Family: | Mrakiaceae |
| Genus: | M.W. Mill., Yoney. & Soneda (1976) |
| Type species | |
| Phaffia rhodozyma M.W. Mill., Yoney. & Soneda (1976)
| |
| Species | |
|
Phaffia aurantiaca | |
| Synonyms | |
|
Xanthophyllomyces Golubev (1995)[1] | |
Phaffia is a genus of fungi in the order Cystofilobasidiales.[1] The genus comprises orange-red yeasts that form basidia directly from yeast cells, lack hyphae throughout their life cycle, and produce astaxanthin, a carotenoid used as an additive in animal feed to enhance colour in shrimp, salmon, and poultry eggs and also as an antioxidant in dietary supplements.[2]
The genus was named after the Dutch specialist Herman Phaff who first isolated the type species from slime fluxes of Japanese and North American trees in the 1960s.[3]
The genus Xanthophyllomyces was proposed for the teleomorphic (basidia-bearing) state of Phaffia. Following changes to the International Code of Nomenclature for algae, fungi, and plants, however, the practice of giving different names to teleomorph and anamorph forms of the same fungus was discontinued, meaning that Xanthophyllomyces became a synonym of the earlier name Phaffia.[1]
References
- ^ a b c Liu XZ, Wang QM, Göker M, Groenewald M, Kachalkin AV, Lumbsch HT, Millanes AM, Wedin M, Yurkov AM, Boekhout T, Bai FY (2015). "Towards an integrated phylogenetic classification of the Tremellomycetes". Studies in Mycology. 81: 85–147. doi:10.1016/j.simyco.2015.12.001. PMC 4777781. PMID 26955199.
- ^ David-Palma M, Libkind D, Brito PH, Silva M, Bellora N, Coelho MA, Heitman J, Gonçalves P, Sampaio JP (2020). "The untapped Australasian diversity of astaxanthin-producing yeasts with biotechnological potential - Phaffia australis sp. nov. and Phaffia tasmanica sp. nov". Microorganisms. 8 (11): 1651. doi:10.3390/microorganisms8111651. hdl:11336/183651. PMC 7692969. PMID 33114402.
- ^ Johnson EA (2003). "Phaffia rhodozyma: colorful odyssey". Int Microbiol. 6 (3): 169–174. doi:10.1007/s10123-003-0130-3. PMID 12898396.